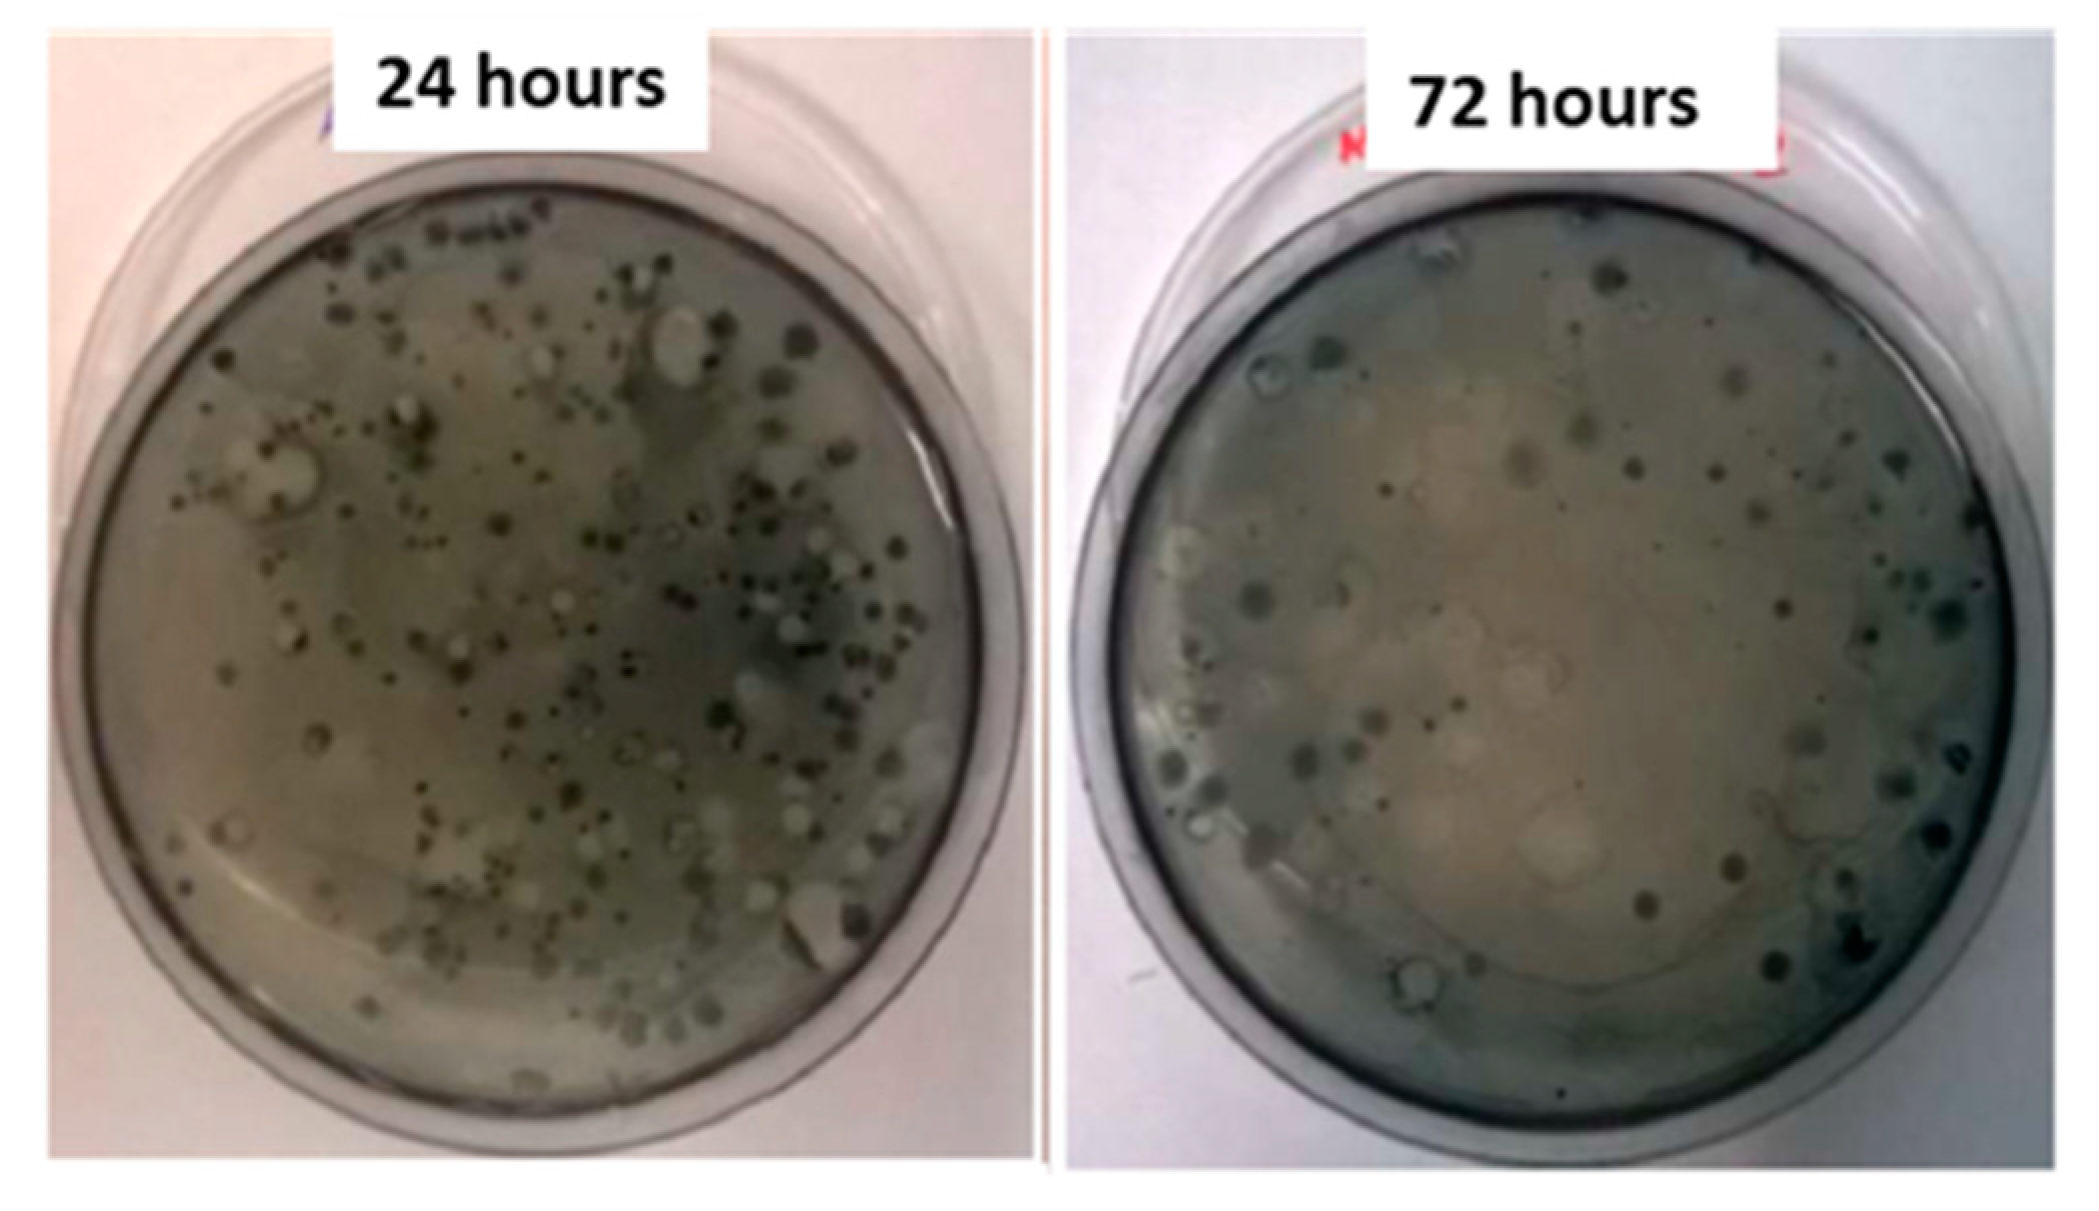

PHA Production from Cheese Whey and “Scotta”: Comparison between a Consortium and a Pure Culture of Leuconostoc mesenteroides
Abstract
:1. Introduction
2. Materials and Methods
2.1. PHA Production with Mixed Microbial Cultures (MMC)
2.1.1. Flask Tests
2.1.2. Bioreactor Tests
2.2. PHA Production with Leuconostoc mesenteroides Isolated from MMC
2.3. PHA Extraction
2.4. Detection of PHA Producing Strains
2.5. Isolation and Identification of PHA-Producing Bacteria
3. Results
3.1. PHA Production with MMC
3.1.1. Flask Tests
3.1.2. Bioreactor Tests
3.2. Isolation and Identification of PHA-Producing Bacteria
3.3. PHA Production with MMC-Isolated L. mesenteroides
4. Discussion
5. Conclusions
Supplementary Materials
Author Contributions
Funding
Institutional Review Board Statement
Informed Consent Statement
Data Availability Statement
Conflicts of Interest
References
- Eriksen, M.; Lebreton, L.C.M.; Carson, H.S.; Thiel, M.; Moore, C.J.; Borerro, J.C.; Galgani, F.; Ryan, P.G.; Reisser, J. Plastic Pollution in the World’s Oceans: More than 5 Trillion Plastic Pieces Weighing over 250,000 Tons Afloat at Sea. PLoS ONE 2014, 9, e111913. [Google Scholar] [CrossRef] [Green Version]
- Bouwmeester, H.; Hollman, P.C.H.; Peters, R.J.B. Potential Health Impact of Environmentally Released Micro- and Nanoplastics in the Human Food Production Chain: Experiences from Nanotoxicology. Environ. Sci. Technol. 2015, 49, 8932–8947. [Google Scholar] [CrossRef]
- Rehm, B.H.A. Bacterial polymers: Biosynthesis, modifications and applications. Nat. Rev. Microbiol. 2010, 8, 578–592. [Google Scholar] [CrossRef] [PubMed]
- Philp, J.C.; Bartsev, A.; Ritchie, R.J.; Baucher, M.-A.; Guy, K. Bioplastics science from a policy vantage point. New Biotechnol. 2013, 30, 635–646. [Google Scholar] [CrossRef] [PubMed]
- Philip, S.; Keshavarz, T.; Roy, I. Polyhydroxyalkanoates: Biodegradable polymers with a range of applications. J. Chem. Technol. Biotechnol. 2007, 82, 233–247. [Google Scholar] [CrossRef]
- Byrom, D. Polyhydroxyalkanoates. In Plastics from Microbes: Microbial Synthesis of Polymers and Polymer Precursors; Mobley, D.P., Ed.; Car Hanser Verlag: Munich, Germany, 1994; pp. 5–33. [Google Scholar]
- Kim, D.Y.; Hyung, W.K.; Moon, G.C.; Young, H.R. Biosynthesis, modification, and biodegradation of bacterial medium-chain-length polyhydroxyalkanoates. J. Microbiol. 2007, 45, 87–97. [Google Scholar] [PubMed]
- Escapa, I.F.; Morales, V.; Martino, V.P.; Pollet, E.; Avérous, L.; García, J.L.; Prieto, M.A. Disruption of β-oxidation pathway in Pseudomonas putida KT2442 to produce new functionalized PHAs with thioester groups. Appl. Microbiol. Biotechnol. 2011, 89, 1583–1598. [Google Scholar] [CrossRef] [PubMed]
- Sudesh, K.; Abe, H.; Doi, Y. Synthesis, structure and properties of polyhydroxyalkanoates: Biological polyesters. Prog. Polym. Sci. 2000, 25, 1503–1555. [Google Scholar] [CrossRef]
- Salehizadeh, H.; van Loosdrecht, M. Production of polyhydroxyalkanoates by mixed culture: Recent trends and biotechnological importance. Biotechnol. Adv. 2004, 22, 261–279. [Google Scholar] [CrossRef]
- Fukui, T.; Doi, Y. Efficient production of polyhydroxyalkanoates from plant oils by Alcaligenes eutrophus and its recombinant strain. Appl. Microbiol. Biotechnol. 1998, 49, 333–336. [Google Scholar] [CrossRef]
- Choi, J.-I.; Lee, S.Y. High-Level Production of Poly(3-Hydroxybutyrate-co-3-Hydroxyvalerate) by Fed-Batch Culture of Recombinant Escherichia coli. Appl. Environ. Microbiol. 1999, 65, 4363–4368. [Google Scholar] [CrossRef] [PubMed] [Green Version]
- Omar, S.; Rayes, A.; Eqaab, A.; Vos, I.; Steinbüchel, A. Optimization of cell growth and poly(3-hydroxybutyrate) accumulation on date syrup by a Bacillus megaterium strain. Biotechnol. Lett. 2001, 23, 1119–1123. [Google Scholar] [CrossRef]
- Huang, T.-Y.; Duan, K.-J.; Huang, S.-Y.; Chen, C.W. Production of polyhydroxyalkanoates from inexpensive extruded rice bran and starch by Haloferax mediterranei. J. Ind. Microbiol. Biotechnol. 2006, 33, 701–706. [Google Scholar] [CrossRef]
- Van-Thuoc, D.; Quillaguamán, J.; Mamo, G.; Mattiasson, B. Utilization of agricultural residues for poly(3-hydroxybutyrate) production by Halomonas boliviensis LC1. J. Appl. Microbiol. 2007, 104, 420–428. [Google Scholar] [CrossRef]
- Bosco, F.; Chiampo, F. Production of polyhydroxyalcanoates (PHAs) using milk whey and dairy wastewater activated sludge: Production of bioplastics using dairy residues. J. Biosci. Bioeng. 2010, 109, 418–421. [Google Scholar] [CrossRef] [PubMed]
- Koller, M.; Bona, R.; Chiellini, E.; Fernandes, E.G.; Horvat, P.; Kutschera, C.; Hesse, P.; Braunegg, G. Polyhydroxyalkanoate production from whey by Pseudomonas hydrogenovora. Bioresour. Technol. 2008, 99, 4854–4863. [Google Scholar] [CrossRef]
- Guimarães, P.M.; Teixeira, J.; Domingues, L. Fermentation of lactose to bio-ethanol by yeasts as part of integrated solutions for the valorisation of cheese whey. Biotechnol. Adv. 2010, 28, 375–384. [Google Scholar] [CrossRef] [Green Version]
- Kim, H.O.K.; Wee, Y.J.; Kim, J.N.; Yun, J.S.; Ryu, H.W. Production of lactic acid from cheese whey by batch and repeated batch cultures of Lactobacillus sp. RKY2. Appl. Biochem. Biotechnol. 2006, 131, 694–704. [Google Scholar] [CrossRef]
- Amaro, T.M.M.M.; Rosa, D.; Comi, G.; Iacumin, L. Prospects for the Use of Whey for Polyhydroxyalkanoate (PHA) Production. Front. Microbiol. 2019, 10, 992. [Google Scholar] [CrossRef] [PubMed]
- Pessione, E. Lactic acid bacteria contribution to gut microbiota complexity: Lights and shadows. Front. Cell. Infect. Microbiol. 2012, 2, 86. [Google Scholar] [CrossRef] [Green Version]
- Bosco, F.; Carletto, R.A.; Marmo, L. An integrated cheese whey valorization process. Chem. Eng. Trans. 2018, 64, 379–384. [Google Scholar] [CrossRef]
- Khardenavis, A.; Sureshkumar, M.; Mudliar, S.; Chakrabarti, T. Biotechnological conversion of agro-industrial wastewaters into biodegradable plastic, poly β-hydroxybutyrate. Bioresour. Technol. 2007, 98, 3579–3584. [Google Scholar] [CrossRef] [PubMed]
- De Man, J.C.; Rogosa, M.; Sharpe, M.E. A medium for the cultivation of lactobacilli. J. Appl. Bacteriol. 1960, 23, 130–135. [Google Scholar] [CrossRef]
- Hahn, S.K.; Chang, Y.K.; Kim, B.S.; Lee, K.M.; Chang, H.N. The recovery of poly(3-hydroxybutyrate) by using dispersions of sodium hypochlorite solution and chloroform. Biotechnol. Tech. 1993, 7, 209–212. [Google Scholar] [CrossRef]
- Chua, A.S.; Takabatake, H.; Satoh, H.; Mino, T. Production of polyhydroxyalkanoates (PHA) by activated sludge treating municipal wastewater: Effect of pH, sludge retention time (SRT), and acetate concentration in influent. Water Res. 2003, 37, 3602–3611. [Google Scholar] [CrossRef]
- Lemos, P.; Serafim, L.; Reis, M.A. Synthesis of polyhydroxyalkanoates from different short-chain fatty acids by mixed cultures submitted to aerobic dynamic feeding. J. Biotechnol. 2006, 122, 226–238. [Google Scholar] [CrossRef]
- Berwig, K.H.; Baldasso, C.; Dettmer, A. Production and characterization of poly(3-hydroxybutyrate) generated by Alcaligenes latus using lactose and whey after acid protein precipitation process. Bioresour. Technol. 2016, 218, 31–37. [Google Scholar] [CrossRef] [PubMed]
- Carletto, R.A.; Chiadò, A.; Gillio, L.; Bosco, F.; Marmo, L. Application of SBB staining technique for monitoring pha production in milk whey fermentation. In Proceedings of the Chemical Engineering Transactions; Italian Association of Chemical Engineering-AIDIC: Milan, Italy, 2011; Volume 24, pp. 487–492. [Google Scholar]
- De Lima, T.C.S.; Grisi, B.M.; Bonato, M.C.M. Bacteria isolated from a sugarcane agroecosystem: Their potential production of polyhydroxyalcanoates and resistance to antibiotics. Rev. Microbiol. 1999, 30, 214–224. [Google Scholar] [CrossRef]
- Sánchez-Juanes, F.; Teixeira-Martín, V.; González-Buitrago, J.M.; Velázquez, E.; Flores-Félix, J.D. Identification of Species and Subspecies of Lactic Acid Bacteria Present in Spanish Cheeses Type “Torta” by MALDI-TOF MS and pheS gene Analyses. Microorganisms 2020, 8, 301. [Google Scholar] [CrossRef] [PubMed] [Green Version]
- Antunes, A.; Rainey, A.F.; Nobre, M.F.; Schumann, P.; Ferreira, A.M.; Ramos, A.; Santos, H.; da Costa, M. Leuconostoc ficulneum sp. nov., a novel lactic acid bacterium isolated from a ripe fig, and reclassification of Lactobacillus fructosus as Leuconostoc fructosum comb. nov. Int. J. Syst. Evol. Microbiol. 2002, 52, 647–655. [Google Scholar] [CrossRef] [Green Version]
- Hemme, D.; Foucaud-Scheunemann, C. Leuconostoc, characteristics, use in dairy technology and prospects in functional foods. Int. Dairy J. 2004, 14, 467–494. [Google Scholar] [CrossRef]
- Sánchez, J.I.; Martínez, B.; Rodríguez, A. Rational selection of Leuconostoc strains for mixed starters based on the physiological biodiversity found in raw milk fermentations. Int. J. Food Microbiol. 2005, 105, 377–387. [Google Scholar] [CrossRef] [PubMed]
- Akaraonye, E.; Keshavarz, T.; Roy, I. Production of polyhydroxyalkanoates: The future green materials of choice. J. Chem. Technol. Biotechnol. 2010, 85, 732–743. [Google Scholar] [CrossRef]
- Kim, S.W.; Kim, P.; Lee, H.S.; Kim, J.H. High production of Poly-?-hydroxybutyrate (PHB) from Methylobacterium organophilum under potassium limitation. Biotechnol. Lett. 1996, 18, 25–30. [Google Scholar] [CrossRef]
- Wang, F.; Lee, S.Y. Poly(3-Hydroxybutyrate) Production with High Productivity and High Polymer Content by a Fed-Batch Culture of Alcaligenes latus under Nitrogen Limitation. Appl. Environ. Microbiol. 1997, 63, 3703–3706. [Google Scholar] [CrossRef] [Green Version]
- Carlozzi, P.; Sacchi, A. Biomass production and studies on Rhodopseudomonas palustris grown in an outdoor, temperature controlled, underwater tubular photobioreactor. J. Biotechnol. 2001, 88, 239–249. [Google Scholar] [CrossRef]
- Mitra, R.; Xu, T.; Xiang, H.; Han, J. Current developments on polyhydroxyalkanoates synthesis by using halophiles as a promising cell factory. Microb. Cell Factories 2020, 19, 1–30. [Google Scholar] [CrossRef]
- Ben Abdallah, M.; Karray, F.; Sayadi, S. Production of Polyhydroxyalkanoates by Two Halophilic Archaeal Isolates from Chott El Jerid Using Inexpensive Carbon Sources. Biomolecules 2020, 10, 109. [Google Scholar] [CrossRef] [Green Version]
- Chanprateep, S. Current trends in biodegradable polyhydroxyalkanoates. J. Biosci. Bioeng. 2010, 110, 621–632. [Google Scholar] [CrossRef]
- Grage, K.; Jahns, A.C.; Parlane, N.; Palanisamy, R.; Rasiah, I.A.; Atwood, J.A.; Rehm, B. Bacterial Polyhydroxyalkanoate Granules: Biogenesis, Structure, and Potential Use as Nano-/Micro-Beads in Biotechnological and Biomedical Applications. Biomacromolecules 2009, 10, 660–669. [Google Scholar] [CrossRef] [PubMed]
- Koskimäki, J.J.; Kajula, M.; Hokkanen, J.; Ihantola, E.-L.; Kim, J.H.; Hautajärvi, H.; Hankala, E.; Suokas, M.; Pohjanen, J.; Podolich, O.; et al. Methyl-esterified 3-hydroxybutyrate oligomers protect bacteria from hydroxyl radicals. Nat. Chem. Biol. 2016, 12, 332–338. [Google Scholar] [CrossRef] [PubMed]
- Batista, M.B.; Teixeira, C.S.; Sfeir, M.Z.T.; Alves, L.P.S.; Valdameri, G.; de Oliveira Pedrosa, F.; Sassaki, G.L.; Steffens, M.B.R.; De Souza, E.M.; Dixon, R.; et al. PHB Biosynthesis Counteracts Redox Stress in Herbaspirillum seropedicae. Front. Microbiol. 2018, 9, 472. [Google Scholar] [CrossRef]
- Obruca, S.; Sedlacek, P.; Slaninova, E.; Fritz, I.; Daffert, C.; Meixner, K.; Sedrlova, Z.; Koller, M. Novel unexpected functions of PHA granules. Appl. Microbiol. Biotechnol. 2020, 104, 4795–4810. [Google Scholar] [CrossRef] [PubMed]
- Bugnicourt, E.; Cinelli, P.; Lazzeri, A.; Álvarez, V. Polyhydroxyalkanoate (PHA): Review of synthesis, characteristics, processing and potential applications in packaging. Express Polym. Lett. 2014, 8, 791–808. [Google Scholar] [CrossRef] [Green Version]
- Bugnicourt, E.; Schmid, M.; Nerney, O.M.; Wildner, J.; Smykala, L.; Lazzeri, A.; Cinelli, P. Processing and Validation of Whey-Protein-Coated Films and Laminates at Semi-Industrial Scale as Novel Recyclable Food Packaging Materials with Excellent Barrier Properties. Adv. Mater. Sci. Eng. 2013, 2013, 1–10. [Google Scholar] [CrossRef] [Green Version]
- Ryu, H.W.; Hahn, S.K.; Chang, Y.K.; Chang, H.N. Production of poly(3-hydroxybutyrate) by high cell density fed-batch culture of Alcaligenes eutrophus with phospate limitation. Biotechnol. Bioeng. 1997, 55, 28–32. [Google Scholar] [CrossRef]
- Tanaka, K.; Katamune, K.; Ishizaki, A. Fermentative production of poly(β-hydroxybutyric acid) from xylose viaL-lactate by a two-stage culture method employing Lactococcus lactis IO-1 and Alcaligenes eutrophus. Can. J. Microbiol. 1995, 41, 257–261. [Google Scholar] [CrossRef]
- Patnaik, P.R. Perspectives in the Modeling and Optimization of PHB Production by Pure and Mixed Cultures. Crit. Rev. Biotechnol. 2005, 25, 153–171. [Google Scholar] [CrossRef]
- Raho, S.; Carofiglio, V.E.; Montemurro, M.; Miceli, V.; Centrone, D.; Stufano, P.; Schioppa, M.; Pontonio, E.; Rizzello, C.G. Production of the Polyhydroxyalkanoate PHBV from Ricotta Cheese Exhausted Whey by Haloferax mediterranei Fermentation. Foods 2020, 9, 1459. [Google Scholar] [CrossRef] [PubMed]
- Lee, E.Y.; Yang, H.S.; Choi, J.E.; Lee, M.R.; Park, J.H. A Study of sewage sludge solubilization by activity of Lactic acid bacteria. Jpn. Soc. Mater. Cycles Waste Manag. 2008, 19, 315. [Google Scholar] [CrossRef]
- Marion, D.; Sylvie, P.; Veronique, R.; Yann, D. Evolution of the Raw Cow Milk Microflora, Especially Lactococci, Enterococci, Leuconostocs and Lactobacilli over a Successive 12 Day Milking Regime. Int. J. Dairy Sci. 2008, 3, 117–130. [Google Scholar] [CrossRef]
- Vaughan, E.E.; David, S.; de Vos, W.M. The lactose transporter in Leuconostoc lactis is a new member of the LacS subfamily of galactoside-pentose-hexuronide translocators. Appl. Environ. Microbiol. 1996, 62, 1574–1582. [Google Scholar] [CrossRef] [PubMed] [Green Version]

| Fermentation Mode | Medium | Time (h) | Biomass Dry Weight (g/L) | PHA (g/L) | YPHA/X (g/g) | PHA Productivity (g/L/h) |
|---|---|---|---|---|---|---|
| Flask | Scotta cheese whey | 48 | 1.2 | 0.42 | 0.35 | 0.0088 |
| Bioreactor | Scotta cheese whey | 29 | 2.043 | 1.065 | 0.52 | 0.037 |
| Toma cheese whey | 24 | 1.171 | 0.439 | 0.37 | 0.018 |
| Colony | Gram Staining | Morphology | API Test | Catalase | API Result | Identification |
|---|---|---|---|---|---|---|
| 1 | Negative | Cocco-rods | E/NE | Positive | Enterobacter cloacae 56.4% (E) Raoultella ornithinolytica 32.7% (E) | Not acceptable |
| 2 | Negative | Rods | E/NE | Negative | Citrobacter freundii 99.9% | Acceptable |
| 3 | Negative | Cocco-rods | E/NE | Positive | Escherichia coli 96.3% (E) Vibrio parahaemoliticus 98.9% (NE) | Not acceptable |
| 4 | Positive | Coccus | STREP | Negative | Leuconostoc spp. 98.5% | Acceptable |
| 5 | Negative | Rods | E/NE | Negative | Citrobacter freundii 99.9% | Acceptable |
| Medium | Time (h) | Biomass Dry Weight (g/L) | PHA (g/L) | YPHA/X (g/g) | PHA Productivity (g/L/h) |
|---|---|---|---|---|---|
| Modified Khardhenavis with glucose | 24 | 0.2350 | 0.0850 | 0.036 | 0.0035 |
| Modified Khardhenavis with lactose | 48 | 0.1565 | 0.0570 | 0.036 | 0.00119 |
Publisher’s Note: MDPI stays neutral with regard to jurisdictional claims in published maps and institutional affiliations. |
© 2021 by the authors. Licensee MDPI, Basel, Switzerland. This article is an open access article distributed under the terms and conditions of the Creative Commons Attribution (CC BY) license (https://creativecommons.org/licenses/by/4.0/).
Share and Cite
Bosco, F.; Cirrincione, S.; Carletto, R.; Marmo, L.; Chiesa, F.; Mazzoli, R.; Pessione, E. PHA Production from Cheese Whey and “Scotta”: Comparison between a Consortium and a Pure Culture of Leuconostoc mesenteroides. Microorganisms 2021, 9, 2426. https://doi.org/10.3390/microorganisms9122426
Bosco F, Cirrincione S, Carletto R, Marmo L, Chiesa F, Mazzoli R, Pessione E. PHA Production from Cheese Whey and “Scotta”: Comparison between a Consortium and a Pure Culture of Leuconostoc mesenteroides. Microorganisms. 2021; 9(12):2426. https://doi.org/10.3390/microorganisms9122426
Chicago/Turabian StyleBosco, Francesca, Simona Cirrincione, Riccardo Carletto, Luca Marmo, Francesco Chiesa, Roberto Mazzoli, and Enrica Pessione. 2021. "PHA Production from Cheese Whey and “Scotta”: Comparison between a Consortium and a Pure Culture of Leuconostoc mesenteroides" Microorganisms 9, no. 12: 2426. https://doi.org/10.3390/microorganisms9122426
APA StyleBosco, F., Cirrincione, S., Carletto, R., Marmo, L., Chiesa, F., Mazzoli, R., & Pessione, E. (2021). PHA Production from Cheese Whey and “Scotta”: Comparison between a Consortium and a Pure Culture of Leuconostoc mesenteroides. Microorganisms, 9(12), 2426. https://doi.org/10.3390/microorganisms9122426

